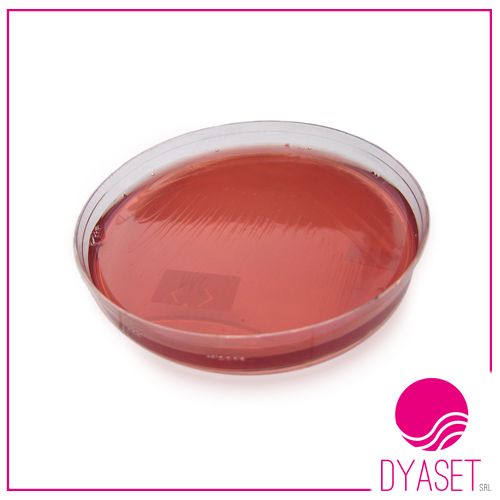
MAC CONKEY AGAR 20PS - immagine 2

Il tuo carrello è attualmente vuoto!
MAC CONKEY AGAR 20PS
Il prezzo originale era: 25,50 €.20,40 €Il prezzo attuale è: 20,40 €.
Terreno in piastra Mac conkey agar
Descrizione
Terreno selettivo Mac Conkey Agar per differenziare in modo ottimale i coliformi ed i batteri non fermentanti il lattosio. Confezione 20 piastre
Prodotti correlati
-
CYTO-BRUSH 50PZ
Il prezzo originale era: 9,50 €.7,60 €Il prezzo attuale è: 7,60 €. -
DERMAKIT 12 test
Il prezzo originale era: 42,00 €.33,60 €Il prezzo attuale è: 33,60 €. -
DTM+SABOURAUD AGAR 20PS
Il prezzo originale era: 28,50 €.22,80 €Il prezzo attuale è: 22,80 €. -
SABOURAUD AGAR 20ps
Il prezzo originale era: 25,50 €.20,40 €Il prezzo attuale è: 20,40 €. -
SANGUE AGAR 20 PS
Il prezzo originale era: 31,50 €.25,20 €Il prezzo attuale è: 25,20 €.

Recensioni
Ancora non ci sono recensioni.